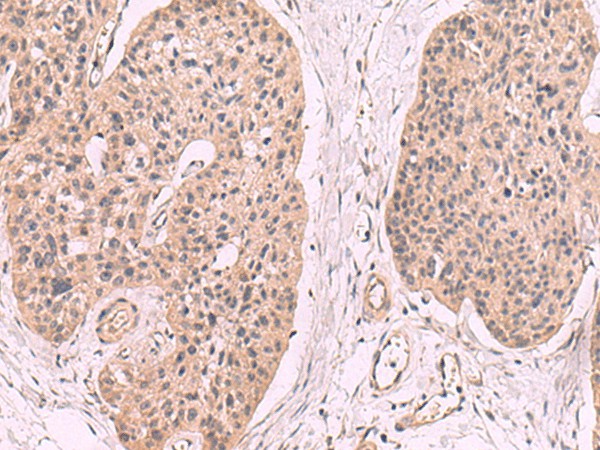
Валидация Elabscience E-AB-52184

| UNIPROT | Q12918 |
| Иммуноген | Гибридный белок, соответствующий человеческому KLRB1 |
KLRB1 Polyclonal Antibody (E-AB-52184)
Реактивность подтвержденная:
человек
Источник (хозяин):
кролик
Валидировано для:
IHC
WB
Характеристики
Техническое описание
| Каталожный номер | E-AB-52184 |
| Название антигена | Killer Cell Lectin Like Receptor Subfamily B, Member 1 (KLRB1) |
| UNIPROT | Q12918 |
| Иммуноген | Гибридный белок, соответствующий человеческому KLRB1 |
| Английские синонимы | CD161, CD 161, CD-161, KLR-B1, CLEC5B, NKR, NKR-P1, NKR-P1A, NKRP1A, HNKR-P1A, C-type lectin domain family 5 member B, Natural killer cell surface protein P1A |
Реактивность подтвержденная Нужна другая реактивность? |
человек |
| Источник (хозяин) | кролик |
| Изотип | IgG |
| Клональность | поликлональное |
| Рекомбинантное | нет |
| Готовое к использованию | нет |
| Концентрация | 1 мг/мл |
| Конъюгат | нет |
| Валидировано для | IHC WB Иммуногистохимия; Вестерн-блоттинг |
| Рекомендуемые разведения | WB 1:500-1:2000; IHC 1:50-1:300 |
| Метод очистки | Аффинная очистка с антигеном |
| Состав буфера | PBS с 0.05% NaN3 и 40% глицерин,pH7.4 |
| Условия доставки | термобокс с аккумуляторами холода |
| Условия хранения | Хранить при -20°C - 12 месяцев. Избегать повторяющихся циклов замораживания/оттаивания |
| Срок хранения | 12 месяцев |
| Производитель | Elabscience |
| Ссылка на страницу товара на сайте производителя | https://www.elabscience.com/p-klrb1_polyclonal_antibody-e_ab_52184 |
|
Артикул
|
Наименование |
Производитель
|
|---|
|
Артикул
|
Наименование |
Производитель
|
|---|
|
Артикул
|
Наименование |
Производитель
|
|---|
|
Артикул
|
Наименование |
Производитель
|
|---|
Акции и предложения
Популярные продукты:
Mouse Claspin(CLSPN) ELISA kit (E03C1815)
Организм: мышь
Rabbit Copine 4(CPNE4) ELISA kit (E04C2013)
Организм: кролик
Mouse Copine 4(CPNE4) ELISA kit (E03C2013)
Организм: мышь
Monkey Folate receptor gamma ELISA kit (E09F0406)
Организм: обезьяна
Rabbit Cullin 9(CUL9) ELISA kit (E04C2188)
Организм: кролик
Rabbit Aminolevulinate Delta Dehydratase ELISA kit (E04A0053)
Организм: кролик
Диапазон определения: 0.5-10 нг/мл
Чувствительность: 0.1 нг/мл
Диапазон определения: 0.5-10 нг/мл
Чувствительность: 0.1 нг/мл